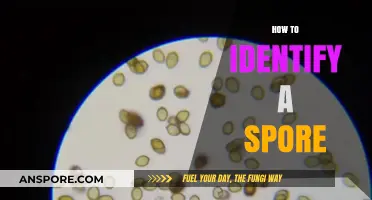
Mastering Spore Identification: Essential Tips for Accurate Detection

Improving a Grox's reputation in *Spore* requires a strategic approach to interactions within the game’s galactic stage. The Grox, known for their aggressive and hostile nature, often start with a negative reputation, making diplomacy challenging. To enhance their standing, players must focus on peaceful actions such as establishing trade routes, gifting resources, and avoiding conflicts with other civilizations. Additionally, completing missions that benefit neighboring empires and aligning with factions that can influence galactic opinion can gradually shift perceptions. Patience and consistent positive engagement are key, as the Grox’s reputation will improve over time with sustained efforts to foster goodwill and cooperation across the galaxy.
| Characteristics | Values |
|---|---|
| Interact Positively | Engage in friendly interactions like singing, dancing, or giving gifts to Grox. |
| Complete Missions | Fulfill missions given by Grox to gain their trust and improve reputation. |
| Avoid Aggression | Refrain from attacking or provoking Grox, as this will damage reputation. |
| Trade Resources | Trade valuable resources with Grox to build positive relationships. |
| Use Diplomatic Tools | Utilize diplomatic abilities like the "Charm" or "Befriend" tools to improve standing. |
| Explore Grox Space | Visit and explore Grox-controlled systems to show interest and respect. |
| Avoid Stealing | Do not steal from Grox or their territories, as this will harm reputation. |
| Ally with Allies | Be friendly with species allied with the Grox to indirectly improve reputation. |
| Time and Patience | Improving Grox reputation takes time; consistent positive actions are key. |
| Avoid Negative Actions | Steer clear of actions that provoke or annoy the Grox, such as trespassing. |
What You'll Learn
- Enhance customer service with quick, personalized responses to all client inquiries and feedback
- Leverage social media to share positive stories, achievements, and engage with the community
- Encourage satisfied customers to leave reviews on trusted platforms like Google or Yelp
- Partner with influencers or industry leaders to boost credibility and visibility
- Consistently deliver high-quality products or services to build long-term trust and loyalty

Enhance customer service with quick, personalized responses to all client inquiries and feedback
In the digital age, where customer expectations are higher than ever, the speed and personalization of responses can make or break a brand’s reputation. For Groxs, improving its standing in the Spore community begins with treating every client inquiry and feedback as a priority. Implement a ticketing system that categorizes messages by urgency, ensuring that critical issues are addressed within 2 hours and general queries within 24 hours. Use customer relationship management (CRM) tools to track interaction history, allowing agents to tailor responses with personal details like the client’s name, past purchases, or previous concerns. This not only resolves issues faster but also fosters a sense of being valued, turning one-time buyers into loyal advocates.
Consider the case of a Spore player who encounters a bug in Groxs’ product and posts about it on a forum. A quick, personalized response acknowledging the issue, offering a temporary workaround, and promising a fix in the next update can transform frustration into appreciation. Train your support team to use a friendly, empathetic tone, avoiding generic templates. For instance, instead of “We’re working on it,” say, “Thanks for bringing this to our attention, [Player Name]. Our team is already on it, and we’ll roll out a fix by [specific date].” Such specificity builds trust and shows commitment to the community’s experience.
However, speed and personalization must be balanced with accuracy. Rushing responses can lead to misinformation or overlooked details, which can damage credibility. To mitigate this, create a knowledge base accessible to both customers and support staff, ensuring consistency in answers. For complex issues, assign a dedicated agent to follow up until resolution, rather than passing the client between departments. Additionally, leverage AI chatbots for immediate acknowledgments, but ensure they escalate to a human agent for nuanced cases. For example, a chatbot can handle FAQs like “How do I install this mod?” while redirecting complaints about compatibility issues to a specialist.
The takeaway is clear: quick, personalized responses are not just about resolving issues but about building relationships. For Groxs, this means integrating customer service into the brand’s identity, making it a differentiator in the Spore market. Start by auditing current response times and personalizing templates with dynamic fields. Gradually, shift focus to proactive communication, such as sending follow-up emails after purchases or engaging with players on Spore forums. By treating customer service as a strategic asset rather than a cost center, Groxs can elevate its reputation from merely functional to exceptional, one interaction at a time.
How Long Do Black Mold Spores Remain Airborne: A Comprehensive Guide
You may want to see also

Leverage social media to share positive stories, achievements, and engage with the community
Social media platforms are powerful tools for reshaping public perception, and Grox’s reputation in *Spore* can benefit significantly from a strategic online presence. Start by identifying and amplifying positive stories—whether it’s a Grox player fostering intergalactic peace, contributing to a thriving ecosystem, or showcasing artistic creations within the game. These narratives counterbalance stereotypes and humanize the Grox, making them more relatable to the *Spore* community. Use platforms like Reddit, Twitter, or TikTok to share screenshots, videos, or anecdotes that highlight these achievements, ensuring they’re tagged with relevant *Spore* or Grox-related hashtags for maximum visibility.
Engagement is the lifeblood of social media, and interacting with the *Spore* community can turn passive observers into active advocates. Respond to comments, participate in forums, and join discussions about the Grox, always steering the conversation toward their potential for good. For instance, if a player shares a story about a Grox-led alliance, amplify it by asking follow-up questions or sharing similar experiences. Caution: avoid defensive or confrontational tones, even when addressing criticism. Instead, use humor, empathy, or constructive dialogue to shift the narrative. For example, a lighthearted meme about Grox being misunderstood can disarm negativity while reinforcing a positive image.
To maximize impact, create a content calendar that balances storytelling, achievements, and community interaction. Post at least 3–4 times weekly, varying formats to keep the audience engaged—short clips, infographics, polls, or even live streams of Grox-focused gameplay. Tools like Canva or CapCut can help polish visuals without requiring professional skills. Additionally, collaborate with *Spore* influencers or content creators to co-create content, leveraging their reach to amplify your message. For instance, a joint video series exploring the Grox’s role in different *Spore* stages could attract a broader audience and lend credibility to your efforts.
Finally, measure success by tracking engagement metrics—likes, shares, comments, and follower growth—but also qualitative feedback, such as shifts in tone within community discussions. Celebrate small wins, like a viral post or a positive comment thread, and use them as case studies to refine your strategy. Remember, rebuilding a reputation takes time, but consistent, authentic engagement on social media can gradually transform the Grox from feared conquerors to respected contributors in the *Spore* universe.
Understanding Mold Spore Inhalation: How They Enter and Affect Humans
You may want to see also

Encourage satisfied customers to leave reviews on trusted platforms like Google or Yelp
Positive reviews from satisfied customers are one of the most powerful tools for building a strong online reputation. They act as social proof, influencing potential customers' decisions and fostering trust in your brand. Think of it as word-of-mouth marketing amplified for the digital age.
Encourage this organic advocacy by making it easy and appealing for happy customers to share their experiences.
Here's a strategic approach:
- Seamless Integration: Integrate review requests into your existing customer journey. After a successful purchase or service completion, send a personalized email or SMS thanking them and including direct links to your Google My Business or Yelp profiles.
- Timing is Key: Don't wait too long. The best time to ask for a review is when the experience is fresh in the customer's mind. Aim for within 24-48 hours after their interaction with your business.
- Make it Personal: Avoid generic, robotic requests. Personalize your message by addressing the customer by name and referencing their specific purchase or experience. A touch of sincerity goes a long way.
- Offer Incentives (Ethically): While you can't bribe customers for positive reviews, you can offer small tokens of appreciation for their time. This could be a discount code, a free sample, or entry into a giveaway. Be transparent about the incentive and emphasize that it's not contingent on the review's content.
Caution: Avoid aggressive tactics or pressuring customers. A genuine, positive review is far more valuable than a coerced one.
Pro Tip: Respond to all reviews, both positive and negative. Thank customers for their feedback and address any concerns promptly and professionally. This demonstrates your commitment to customer satisfaction and encourages further engagement.
By actively encouraging satisfied customers to share their positive experiences on trusted platforms, you'll cultivate a robust online reputation that attracts new customers and strengthens your brand's credibility. Remember, authenticity and gratitude are key to building a thriving online community around your business.
Hydrogen Peroxide's Effectiveness Against Tetanus Spores: Fact or Fiction?
You may want to see also

Partner with influencers or industry leaders to boost credibility and visibility
In the digital ecosystem of Spore, where reputation is currency, partnering with influencers or industry leaders can act as a catalyst for Grox’s credibility and visibility. These collaborations leverage the trust and reach of established figures, effectively bypassing the slow grind of organic reputation building. For instance, a single endorsement from a renowned space explorer or a trade guild leader can position Grox as a trusted entity among interstellar communities. The key lies in identifying partners whose values align with Grox’s goals, ensuring authenticity in the partnership.
To execute this strategy, start by mapping out potential collaborators within Spore’s diverse factions—from the eco-conscious Grox to the tech-savvy robotic empires. Reach out with a clear value proposition: what can Grox offer in return for the influencer’s endorsement? This could range from exclusive trade deals to joint ventures in resource-rich systems. For example, partnering with a popular space cartographer could result in Grox territories being prominently featured on interstellar maps, increasing visibility to traders and explorers alike.
However, caution is essential. Misaligned partnerships can backfire, tarnishing Grox’s reputation instead of enhancing it. Avoid influencers known for controversial alliances or unethical practices. Conduct thorough research using Spore’s intergalactic databases to vet potential collaborators. Additionally, ensure the partnership is mutually beneficial—a one-sided deal may lead to resentment and negative publicity. For instance, if a trade guild leader promotes Grox but receives subpar goods in return, the fallout could damage Grox’s standing across multiple sectors.
The takeaway is clear: strategic influencer partnerships are a high-impact, low-effort way to elevate Grox’s reputation in Spore. By aligning with respected figures, Grox can tap into established networks, gain credibility, and increase visibility exponentially. However, success hinges on careful selection, mutual benefit, and authenticity. Done right, this approach can transform Grox from a minor player into a galactic powerhouse, respected across the stars.
Mastering Spore Creature Editor: Adding Detailed Cell Parts to Your Designs
You may want to see also

Consistently deliver high-quality products or services to build long-term trust and loyalty
In the intricate ecosystem of Spore, where Groxs thrive or fade based on their reputation, the cornerstone of enduring success lies in the consistent delivery of high-quality products or services. Think of it as the evolutionary advantage that sets your Grox apart—reliability breeds trust, and trust fosters loyalty. Whether you’re crafting tools, trading resources, or offering unique services, every interaction is a chance to reinforce your reputation. For instance, if your Grox consistently provides durable, well-crafted items, other creatures will seek you out, knowing they can depend on your offerings. This reliability becomes your signature, a silent promise that resonates across the galaxy.
To achieve this, start by defining what "high-quality" means in your context. Is it the durability of your creations, the efficiency of your services, or the uniqueness of your designs? For example, if you specialize in crafting weapons, ensure they outperform competitors’ in both function and aesthetics. Use premium materials, invest time in intricate designs, and test each product rigorously. In Spore, where word spreads quickly, a single subpar item can tarnish your reputation faster than you can repair it. Conversely, a consistently superior product becomes a benchmark, turning your Grox into a trusted name.
However, consistency isn’t just about the end product—it’s also about the process. Establish a routine for quality control, whether it’s inspecting raw materials, refining techniques, or gathering feedback from other creatures. For instance, if you’re trading resources, ensure every batch meets the same high standards. If you’re offering services, like guiding expeditions or mediating disputes, deliver them with unwavering professionalism. Over time, this reliability becomes your brand, a silent contract that reassures others they’re in good hands. Remember, in Spore, reputation is currency, and consistency is the mint that stamps its value.
One practical tip is to leverage the game’s mechanics to your advantage. Use the Sporepedia to showcase your best work, creating a portfolio that highlights your expertise. Share your creations with other players, and encourage them to leave reviews or recommendations. Positive feedback acts as social proof, reinforcing your reputation and attracting more clients. Additionally, stay attuned to the needs of your community. If other creatures are struggling with a particular challenge, tailor your offerings to address it. For example, if there’s a shortage of efficient vehicles, design and distribute models that fill that gap. By aligning your services with the demands of your environment, you position yourself as both reliable and indispensable.
Finally, beware of the pitfalls of complacency. Even the most trusted Grox can falter if they stop innovating or maintaining their standards. Regularly update your skills, experiment with new techniques, and stay informed about emerging trends. For instance, if a new material becomes available, incorporate it into your designs to stay ahead of the curve. Similarly, if feedback suggests areas for improvement, act on it promptly. Consistency doesn’t mean stagnation—it means evolving while staying true to your commitment to quality. In the ever-changing universe of Spore, this balance is what transforms a fleeting reputation into a lasting legacy.
Magnolia Reproduction: Do These Trees Produce Spores or Seeds?
You may want to see also
Frequently asked questions
Improving Grox's reputation involves interacting positively with other empires, avoiding aggressive actions, and engaging in diplomatic missions. Trade, gifting spices, and allying with other empires can gradually shift their perception of the Grox.
Yes, attacking or destroying other empires will significantly harm Grox's reputation. Focus on peaceful interactions and avoid hostile actions to improve standing with other civilizations.
While mods can alter gameplay, improving reputation is best achieved through in-game actions like diplomacy, trade, and alliances. No official tools exist to directly change reputation without effort.
Improving reputation takes time and consistent effort. Focus on building positive relationships through trade, alliances, and avoiding conflict. The process can span several in-game years depending on your actions.